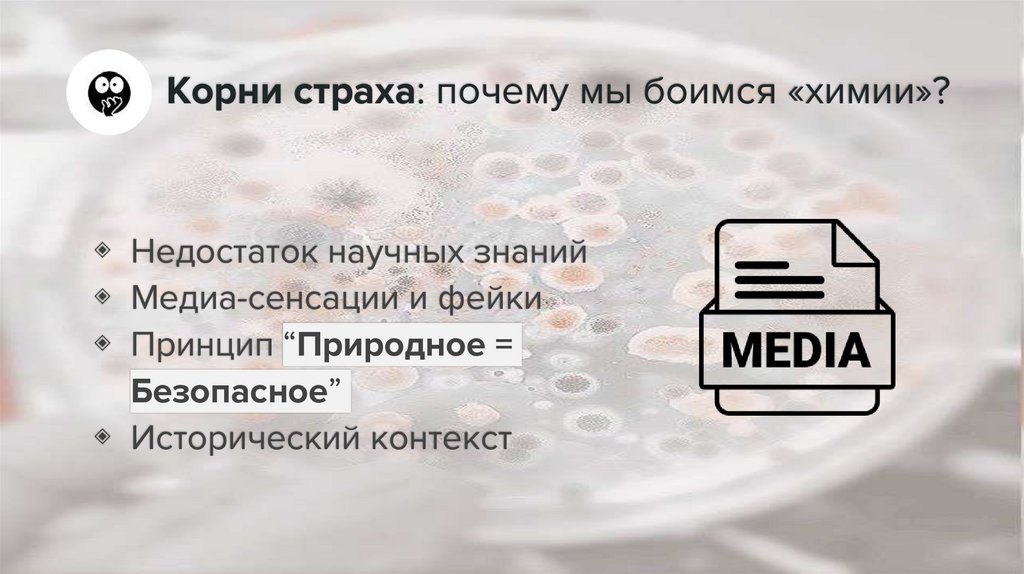
Корни страха: почему мы боимся «химии»?

Similar presentations:
Хемофобия_281 лицей
1. Хемофобия: оправдан ли страх перед «химией» в еде и лекарствах?
Государственное бюджетное общеобразовательноеучреждение Лицей № 281 Адмиралтейского района СанктПетербурга
Хемофобия: оправдан ли страх
перед «химией» в еде и лекарствах?
Авторы работы:
ученики 10”Б” класса, Давыдов И., Прокудин К., Косинова Д.
Дроботова С., Сайфутдинова Д., Кузькова Е.
Научный
руководитель:
Отеллина О.В.,
учитель биологии
2. Хемофобия: враг внутри нас?
Хемофобия –иррациональный страх
перед химическими
веществами!
3. Корни страха: почему мы боимся «химии»?
◈ Недостаток научных знаний◈ Медиа-сенсации и фейки
◈ Принцип “Природное =
Безопасное”
◈ Исторический контекст
4. Химия в еде: Мифы и реальность
Всё вокруг нас – химия, и мы сами состоим из неё!5. Е-добавки: Друзья или враги?
◈ Допущенные Е-добавки = Безопасные и Изученные◈ Они продлевают срок хранения, улучшают вкус и внешний вид,
делая пищу доступной и безопасной
куркумин
аскорбиновая кислота
бетанин
6. Но не все так радужно… Когда Е-шки действительно опасны?
◈ Доза выше допустимой суточнойнормы
◈ Индивидуальная непереносимость
◈ Нитрит натрия Е250 в мясных
полуфабрикатах
7. Химия в лекарствах: спасение или угроза?
◈ Ацетилсалициловая кислота(аспирин)
◈ Пенициллин
◈ Хлорирование воды
8. Доза делает яд – принцип Парацельса!
Sola dosis facit venenum….«Всё есть яд, и ничто не лишено
ядовитости; одна лишь доза
делает яд незаметным».
9. Химия – двигатель прогресса и наш спаситель!
◈ Продовольственнаябезопасность
◈ Здоровье и долголетие
◈ Технологии и инновации
◈ Гигиена и комфорт
10. Как бороться с хемофобией?
Вооружаемся знаниями, а не страхом!◈ Критическое мышление
◈ Надежные источники
информации
◈ Основы химии и биологии
◈ Помнить о принципе
Парацельса!
11. Выбор за нами: страх или прогресс?
Сделай правильный выбор!Вместо того чтобы бояться,
давайте стремиться понять!